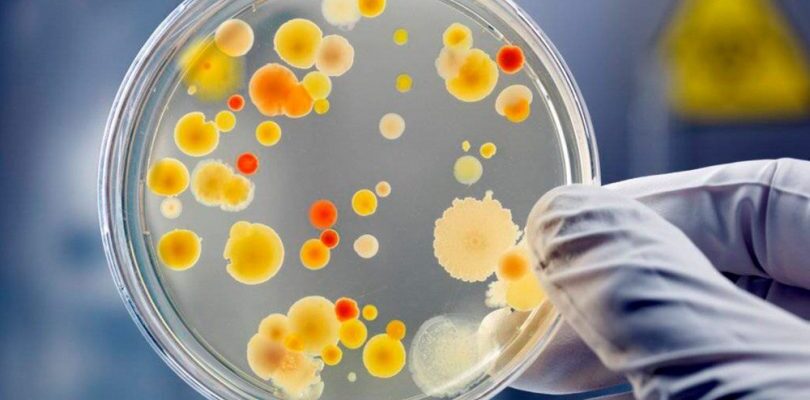

Болезни и лечение
Если начать изучение особенностей диет для похудения, а также лечебных меню, у них можно заметить несколько общих моментов – например, рекомендация готовить
Заболевания эндокринной системы у женщин встречаются с такой же частотой, как и гинекологические, однако о них известно намного меньше. В частности, мало
Чтобы женщина смогла познать счастье материнства, ее репродуктивная система должна работать слаженно, как часовой механизм. Под воздействием различных
Вы привыкли всегда выглядеть безупречно? Идеальный макияж, стильная одежда и даже дорогой парфюм не смогут отвлечь внимание от вашей проблемы – перхоти.
Прыщи, акне, угревая сыпь – все это заставляет содрогаться человека, который хотя бы раз в жизни сталкивался с такой проблемой. Мало того, что прыщи доставляют
Любая женщина расстроится, если обнаружит жировики на половых губах. Хотя они и не доставляют физического дискомфорта, это крайне неприятно. В действительности
Среди прочих анальгетиков Кеторол отличается самым ярко выраженным обезболивающим эффектом, вследствие чего из остальных НПВС используется чаще всего.
Пожалуй, трудно отыскать хозяйку, которая не выращивала бы в домашних условиях алоэ. Лечебные свойства и противопоказания столетника известны человечеству
Вирус Коксаки поражает желудочно-кишечный тракт малыша, но по мере прогрессирования затрагивает ткани и другие внутренние органы, провоцируя воспалительные
В развитых странах одной из наиболее частых причин летального исхода является инфаркт миокарда. Лечение недуга, проведенное правильно, спасает жизнь и